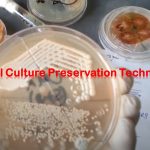
Fungal Culture Preservation- The main objectives of fungal culture are to grow the organisms, isolate the organisms, and if necessary preserve the organisms. A fungal culture is a genetic resource and thus fungal culture preservation is applicable for the following purposes; Germplasm conservation Developmental studies Industrial Application Research programs

Category: Uncategorized
Negative Staining for Bacterial Capsule Demonstration: Introduction, Principle, Procedure and Result Interpretation
 Introduction of Negative Staining for Bacterial Capsule Demonstration Negative staining...
Introduction of Negative Staining for Bacterial Capsule Demonstration Negative staining...
Fungal Culture Preservation: Introduction, Techniques and Detals About Sterile Water Preservation Technique
Fungal Culture Preservation The main objectives of fungal culture are...
Fungal Culture Preservation The main objectives of fungal culture are...
BD BACTEC Blood culture system: Introduction, Principle and Processing
 BD BACTEC Blood Culture System Introduction BD BACTEC Blood Culture System...
BD BACTEC Blood Culture System Introduction BD BACTEC Blood Culture System...
